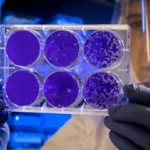
Crisis or Just a Risk Evaluating

Latest Posts
Finding the Best Lawyer for Your Needs: A Guide
The greatest attorney to defend you and assist you in getting a…
7 Reasons Why Instagram Is So Popular Among Brands
Social media is the key to successful marketing in today’s world. But…
Market Trends: Analyzing the Latest Developments in the Stock Market
Are you looking to stay ahead of the curve regarding market trends?…
Recruitment Process Outsourcing vs In-House Hiring: Key Considerations for Businesses
Acquiring the appropriate personnel has become a critical strategic goal for organisations…
4 Trends Shaping The Future of The CBD Business In 2023
The cannabidiol market has quietly become one of the most exciting sectors…
How To Boost Your Med School Application
Choosing a good medical school is vital for your education, training, and…
How Many Views on YouTube Do I Need to Earn at Least $100?
One of the most widely used platforms for content creators to promote…
Instagram Bots: Understanding and Debugging
If you want to gain and retain followers, Instagram can be a…
5 Important Steps to Take When Filing a Wrongful Death Claim
Losing a loved one is a painful and devastating experience that can…
Construction Site Liability: Holding Contractors and Owners Accountable
In recent years, the construction industry in Boston has experienced rapid growth,…
Student Journalism: Opportunities and Platforms in Online News Magazines
Many students choose journalism as their major. It’s a very important profession…
HR Considerations to Contemplate When Selling a Dental Practice
When it comes to selling a dental practice, monumental decisions don't come…
How Can B2B Market Research Agencies React To The Future Development Of Customer Experience?
As customer expectations continue to evolve, driven by advancements in technology, it…
The Role of Education and Awareness in Promoting Good Breathing Air QualityTesting in Industrial Workspaces
One critical factor that frequently goes undetected in the hustle and bustle…
Digitalization of Your Asset Maintenance Management
Digitalization means the use of digital technologies to improve or change business…